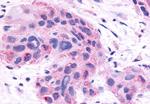
NR0B2 Antibody in Immunohistochemistry (Paraffin) (IHC (P))
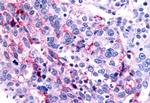
NR0B2 Antibody in Immunohistochemistry (Paraffin) (IHC (P))

Search
Invitrogen
NR0B2 Polyclonal Antibody
{{$productOrderCtrl.translations['antibody.pdp.commerceCard.promotion.promotions']}}
{{$productOrderCtrl.translations['antibody.pdp.commerceCard.promotion.viewpromo']}}
{{$productOrderCtrl.translations['antibody.pdp.commerceCard.promotion.promocode']}}: {{promo.promoCode}} {{promo.promoTitle}} {{promo.promoDescription}}. {{$productOrderCtrl.translations['antibody.pdp.commerceCard.promotion.learnmore']}}

Please note: We are reviewing Western blot images included in the antibody testing data in our catalog, including those provided by third parties. Unless expressly labeled or annotated as “raw-unedited”, Western blot images included in the antibody testing data in our catalog may have been edited, optimized or otherwise adjusted for presentation.
产品信息
PA5-33995
种属反应
宿主/亚型
分类
类型
抗原
偶联物
形式
浓度
规格
纯化类型
保存液
内含物
保存条件
运输条件
RRID
产品详细信息
Percent identity with other species by BLAST analysis: Human, Gorilla, Gibbon, Monkey, Marmoset, Mouse, Hamster, Rabbit (100%) Rat, Bovine, Bat (94%).
靶标信息
The protein encoded by this gene is an unusual orphan receptor that contains a putative ligand-binding domain but lacks a conventional DNA-binding domain. The gene product is a member of the nuclear hormone receptor family, a group of transcription factors regulated by small hydrophobic hormones, a subset of which do not have known ligands and are referred to as orphan nuclear receptors. The protein has been shown to interact with retinoid and thyroid hormone receptors, inhibiting their ligand-dependent transcriptional activation. In addition, interaction with estrogen receptors has been demonstrated, leading to inhibition of function. Studies suggest that the protein represses nuclear hormone receptor-mediated transactivation via two separate steps: competition with coactivators and the direct effects of its transcriptional repressor function.
仅用于科研。不用于诊断过程。未经明确授权不得转售。
篇参考文献 (0)
生物信息学
蛋白别名: Nr0b2a; Nuclear receptor subfamily 0 group B member 2; nuclear receptor subfamily 0 group B member 2-like protein; nuclear receptor subfamily 0, group B, member 2; Orphan nuclear receptor SHP; short heterodimer partner; Small heterodimer partner
基因别名: NR0B2; SHP; SHP-1; Shp1
UniProt ID: (Mouse) Q62227
Entrez Gene ID: (Rabbit) 100357662, (Chinese hamster) 100769023, (Mouse) 23957



